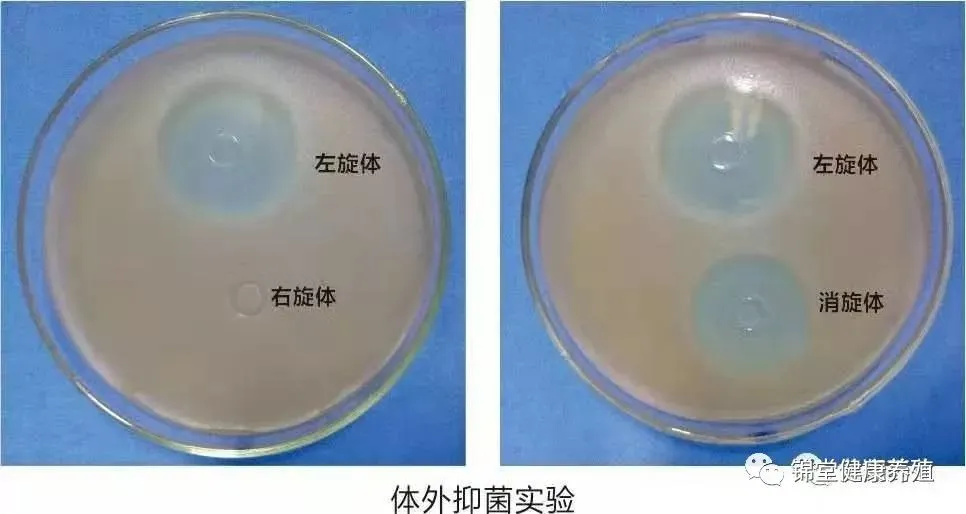

河南锦堂牧业2026年4月5日猪市行情播报(稳中有跌!)
氟苯尼考有两个同分异构体,即分子组成、分子量完全一样,但空间结构不一样。就像人的左右手一样,组成成分完全一样,但不能完全重叠。 ----称之为手性物质,用光学纯度来区分,我们称之为左旋体及右旋体。
抑菌实验表明:左旋体活性最强,右旋体无抗菌活性,左右旋体混合物即消旋体活性次之。由于国家现在提倡无抗饲养,所以采食正常健康畜禽是不能添加氟苯尼考预防疾病,一般都是生病情况下做治疗用。而生病一般情况下畜禽采食量下降,饮水增多,规模饲养情况下,饮水给药方便快捷。氟苯尼考本身是微溶于水,所以,它的治疗效果基本上取决于它的工艺。工艺越好,溶水性越好,它的吸收率也会越好,在体内生物活性就越高,最终提高疗效。
采用先进的手性诱导纯化结晶工艺,龙翔氟苯尼考成品的光学纯度>99%。

手性专利检测技术
1、龙翔氟苯尼考中有抗菌活性的含量高于其它厂家产品5-8%2、其它厂家氟苯尼考中无抗菌活性的异构体含量高于龙翔产品5-8%这也是为什么欧洲、日本客户选择龙翔产品的原因。
龙翔富康采用先进包合工艺,选用进口高品质包合材料,使得氟苯尼考超强水溶,体内有效浓度高,抗菌性更强。1、超强水溶性:采用分子包合工艺,实现氟苯尼考的超强水溶,溶解度高达6000ppm以上。2、水溶性稳定:药物分子与载体分子结合稳定,不受温度、时间、湿度等因素影响;其水溶性静置12小时,无降解、无沉淀产生。3、制剂杂质低:先进的工艺过程,减少药物在生产过程中杂质产生,提高药效、安全性,减少药物在体内副作用,保障食用动物安全。

河南锦堂牧业科技有限公司——作为规模养殖专业服务商,始终秉承“优质产品、专业服务、助力养殖能效提升”的发展理念,全力打造规模养殖专业服务平台,为推动养殖业健康持续发展贡献力量!